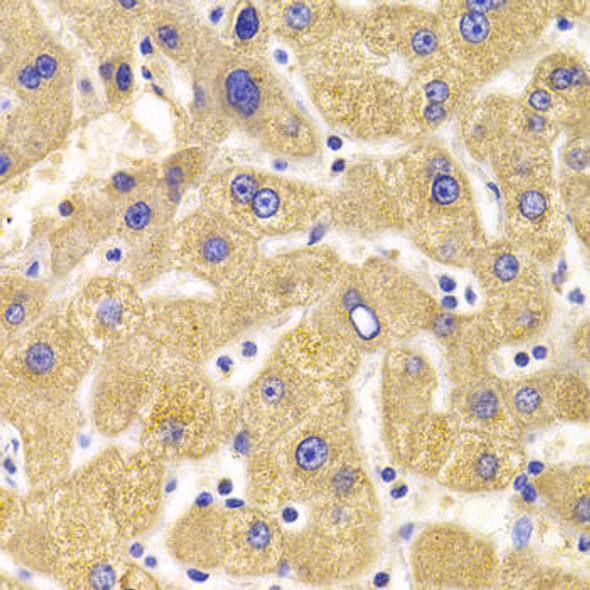
Anti-KIF1B Antibody (CAB6638) Anti-KIF1B Antibody (CAB6638)

Cell Death
- Product
- Qty in Cart
- Quantity
- Price
- Subtotal
-

Anti-RTKN Antibody (CAB6732)
Cell Death Antibodies 2
// system_update_altDatasheetsystem_update_altMSDSOverviewAntibody Name:Anti-RTKN Antibody Antibody SKU:CAB6732Antibody Size:20uL, 50uL, 100uLApplication:WB IFReactivity:Human, MouseHost Species:RabbitImmunogen:Recombinant fusion protein containing a...Qty in Cart: 0Price:Subtotal: -

Anti-RALB Antibody (CAB6714)
Cell Death Antibodies 2
// system_update_altDatasheetsystem_update_altMSDSOverviewAntibody Name:Anti-RALB Antibody Antibody SKU:CAB6714Antibody Size:20uL, 50uL, 100uLApplication:WBReactivity:Human, Mouse, RatHost Species:RabbitImmunogen:Recombinant fusion protein containing a...Qty in Cart: 0Price:Subtotal: -

Anti-PUF60 Antibody (CAB6709)
Cell Death Antibodies 2
// system_update_altDatasheetsystem_update_altMSDSOverviewAntibody Name:Anti-PUF60 Antibody Antibody SKU:CAB6709Antibody Size:20uL, 50uL, 100uLApplication:WB IHC IF IPReactivity:Human, Mouse, RatHost Species:RabbitImmunogen:Recombinant fusion protein...Qty in Cart: 0Price:Subtotal: -
![Anti-NFKB1 Antibody (CAB6667)[KO Validated] Anti-NFKB1 Antibody (CAB6667)[KO Validated]](https://cdn11.bigcommerce.com/s-rd6ounxcu2/images/stencil/590x590/products/46939/51683/anti-nfkb1-antibody-cab6667ko-validated__36744__49834.1706525136.jpg?c=1)
Anti-NFKB1 Antibody (CAB6667)[KO Validated]
KO Validated Antibodies 1
// system_update_altDatasheetsystem_update_altMSDSOverviewAntibody Name:Anti-NFKB1 Antibody [KO Validated] Antibody SKU:CAB6667Antibody Size:20uL, 50uL, 100uLApplication:WB IHC IFReactivity:Human, MouseHost Species:RabbitImmunogen:Recombinant fusion...Qty in Cart: 0Price:Subtotal: -
Anti-KIF1B Antibody (CAB6638)
Cell Death Antibodies 2
// system_update_altDatasheetsystem_update_altMSDSOverviewAntibody Name:Anti-KIF1B Antibody Antibody SKU:CAB6638Antibody Size:20uL, 50uL, 100uLApplication:WB IHCReactivity:Human, Mouse, RatHost Species:RabbitImmunogen:Recombinant fusion protein...Qty in Cart: 0Price:Subtotal: -

Anti-CTNNBL1 Antibody (CAB6572)
Cell Death Antibodies 2
// system_update_altDatasheetsystem_update_altMSDSOverviewAntibody Name:Anti-CTNNBL1 Antibody Antibody SKU:CAB6572Antibody Size:20uL, 50uL, 100uLApplication:WB IFReactivity:Human, Mouse, RatHost Species:RabbitImmunogen:Recombinant fusion protein...Qty in Cart: 0Price:Subtotal: -

Anti-CHIA Antibody (CAB6558)
Cell Death Antibodies 2
// system_update_altDatasheetsystem_update_altMSDSOverviewAntibody Name:Anti-CHIA Antibody Antibody SKU:CAB6558Antibody Size:20uL, 50uL, 100uLApplication:WB IHCReactivity:Human, Mouse, RatHost Species:RabbitImmunogen:Recombinant fusion protein containing...Qty in Cart: 0Price:Subtotal: -

Anti-DDIT3 / CHOP Antibody (CAB6504)
Cell Death Antibodies 2
// system_update_altDatasheetsystem_update_altMSDSOverviewAntibody Name:Anti-DDIT3 / CHOP Antibody Antibody SKU:CAB6504Antibody Size:20uL, 50uL, 100uLApplication:WB IHC IFReactivity:Human, Mouse, RatHost Species:RabbitImmunogen:Recombinant protein of...Qty in Cart: 0Price:Subtotal: -

Anti-RFFL Antibody (CAB6489)
Cell Death Antibodies 2
// system_update_altDatasheetsystem_update_altMSDSOverviewAntibody Name:Anti-RFFL Antibody Antibody SKU:CAB6489Antibody Size:20uL, 50uL, 100uLApplication:WBReactivity:Human, Mouse, RatHost Species:RabbitImmunogen:Recombinant fusion protein containing a...Qty in Cart: 0Price:Subtotal: -

Anti-BCL2L14 Antibody (CAB6478)
Cell Death Antibodies 2
// system_update_altDatasheetsystem_update_altMSDSOverviewAntibody Name:Anti-BCL2L14 Antibody Antibody SKU:CAB6478Antibody Size:20uL, 50uL, 100uLApplication:WB IFReactivity:Human, Mouse, RatHost Species:RabbitImmunogen:Recombinant fusion protein...Qty in Cart: 0Price:Subtotal: -

Anti-NGB Antibody (CAB6477)
Cell Death Antibodies 2
// system_update_altDatasheetsystem_update_altMSDSOverviewAntibody Name:Anti-NGB Antibody Antibody SKU:CAB6477Antibody Size:20uL, 50uL, 100uLApplication:WB IFReactivity:Human, Mouse, RatHost Species:RabbitImmunogen:Recombinant fusion protein containing a...Qty in Cart: 0Price:Subtotal: -

Anti-PTRH2 Antibody (CAB6466)
Cell Death Antibodies 2
// system_update_altDatasheetsystem_update_altMSDSOverviewAntibody Name:Anti-PTRH2 Antibody Antibody SKU:CAB6466Antibody Size:20uL, 50uL, 100uLApplication:WB IHC IFReactivity:Human, Mouse, RatHost Species:RabbitImmunogen:Recombinant fusion protein...Qty in Cart: 0Price:Subtotal:
